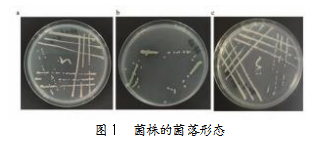

微生物降解有机污染物在废水处理中的效果研究论文
2026-04-02 16:27:23 来源: 作者:xuling
摘要:文章系统设计实验材料与方法,获得微生物降解有机污染物的实验结果,比较不同菌群的降解效率差异,并结合国内外微生物治理技术的新进展进行综合分析。
摘要:微生物降解技术是利用特定菌株代谢活动将有机污染物转化为无毒产物,当前功能强化型合成菌群构建技术与基因编辑微生物等新技术不断涌现,在高效复合菌剂开发与厌氧-好氧协同降解等方面取得了多项突破。文章系统设计实验材料与方法,获得微生物降解有机污染物的实验结果,比较不同菌群的降解效率差异,并结合国内外微生物治理技术的新进展进行综合分析。
关键词:微生物降解;有机污染物;废水处理;效果
微生物代谢通路能够实现有机污染物生物降解,随着高通量测序等技术的发展,微生物对芳香族化合物与酚类衍生物等的降解路径逐步清晰,为精准调控菌群结构及增强降解通量奠定了基础,国内外在耐受性强化菌株筛选与合成微生物群落设计等方面持续获得突破,优化生物处理系统的稳定性,在更高排放标准下揭示微生物降解行为并比较不同功能菌群的降解能力,以分析降解作用机制,推动废水处理技术创新。
1实验材料与方法
1.1实验材料
实验材料包括功能微生物菌株、模拟有机污染物基质、培养基体系等。微生物菌株来源于长期从污水生化池中分离获得的优势降解菌群,涵盖典型芳香族化合物降解菌与烷烃氧化菌等菌群,实验前均采用固体营养琼脂对其进行分离培养。图1为菌株活化及纯化阶段培养皿生长情况,其中图1(a)菌株呈现较强生长扩散性,图1(b)菌株形成规则圆形菌落,而图1(c)菌株在条划区域表现出明显的可延展特性。
污染物基质包括苯酚与甲基橙等典型易测定化合物,为符合国际最新研究趋势,加入部分难降解污染物如多环芳烃中间体,旨在评估菌群在复杂基质条件下的降解潜力[1]。
1.2实验设计
采用分组对比方式,将优势菌株分别设定为单菌体系、多菌复配体系及功能合成菌群体系,在相同初始底物浓度与溶解氧水平等条件下进行平行实验,以确保降解性能。实验基质设置易降解与难降解两类污染物,模拟一般工业废水与高强度复杂废水中常见的污染负荷差异。反应体系采用传统振荡培养模式与静态生物膜模式,同时包括近年来国际研究中的微型连续流动生物反应体系,考察微生物降解动态。实验中引入先进装备与新材料,包括国内最新研发的智能曝气调控装置,可自动调节溶解氧水平,保持反应体系活性区间。采用国际上常用的纳米载体生物膜材料强化菌群固定化能力,同时利用在线监测系统实时记录化学需氧量与溶解氧耗氧量等变化。在菌群构建方面,参考近年来国际合成生物学研究成果,将功能互补菌株形成稳定合成菌群,以模拟多菌协同降解过程。降解结束后进行残留污染物浓度测定,并结合显微观察探究不同菌群的降解行为[2]。
1.3实验步骤
菌株处理阶段,将预先筛选的功能菌株接种于恒温振荡培养箱中进行活化培养,确保菌体获得最稳定的降解活性;培养结束后采用离心收集,同时用无机盐溶液洗涤去除残留营养基质,随后按照实验设计调整菌体浓度,使其初始菌量保持一致;构建反应体系,将模拟废水基质与目标有机污染物按设定浓度进行配置,加入反应容器,将菌体接种至各实验组,同时设置空白对照与灭活菌对照。实验中,利用智能曝气调控系统提高监测精度,实时维持溶解氧在适宜区间,避免降解效率发生变化;引入国际常用的纳米生物膜载体,形成稳定附着结构以模拟生物膜行为,采用在线仪器记录溶解氧变化与pH变化等,并定时取样测定化学需氧量、目标污染物浓度及菌体密度,以评估菌群活性。终点分析阶段,进行过滤处理,然后测定污染物残留定量,开展菌群结构分析、关键酶活性测定、代谢中间产物检测,揭示不同菌群存在的差异,同时结合国际最新研究趋势对比合成菌群与耐受强化菌株等表现[3]。
2实验结果与讨论
2.1微生物对有机污染物降解的实验结果
不同微生物体系在有机污染物降解过程中存在效率差异,微生物降解法整体表现优于传统处理技术,在难降解污染物分解速率上具有更高的稳定性。如图2所示,在样本序号1~7的连续监测过程中,微生物降解法对应的纯净度曲线始终保持在较高水平,基本稳定在0.75~0.90区间,远高于文献[1]和文献[2]所采用的传统氧化法及物化法,表明微生物体系能够在污染物浓度逐渐降低中保持较高的降解活性[4]。

2.2不同菌群的降解效果比较
对比3种(单一功能菌群、复合菌群、合成微生物群落)不同菌群有机污染物的降解过程,分析其在不同条件下的降解效果,包括降解速率与底物转化效率等参数,实验结果表明不同菌群降解效果存在明显差异。表1为相同实验条件下不同菌群对苯酚(C6H6OH)、甲基橙(MO)与乙酸乙酯(EA)等典型有机污染物降解的效果,数据涵盖降解时间与残留浓度等。

为确保菌群比较的准确性,本文明确3类菌群体系的组成。
单菌体系:选用3株前期筛选中表现出稳定降解性能的功能菌株,分别为噬甲酚假单胞菌Pseudomonas putida G-01、蜡样芽孢杆菌Bacillus cereus B-12、赛氏不动杆菌Acinetobacter seifertii A-07,3株菌分别在芳香族化合物氧化、偶氮结构断裂及酯类物质水解中具有优势,能够代表单一功能菌的降解能力。
多菌复配体系:由5种降解互补菌株组成,在单菌体系的3株菌基础上,加入红球菌Rhodococcus erythropolis R-03与睾丸单胞菌Comamonas testosteroni C-16,前者在烷烃氧化过程中活性突出,后者在酚类化合物开环代谢中具备优势,整体形成对多类型污染物更具适应性的复配菌群。
功能合成菌群体系:由6种功能互补菌株构成,以复配体系的5株菌为核心,额外引入枯草芽孢杆菌Bacillus subtilis BS-99,该体系使不同菌株在生物膜附着、信号分泌调控等方面形成稳定协同关系,从而在底物转化通量与降解速率方面表现出更高水平[5]。
3结语
综上所述,微生物代谢能够实现有机污染物生物降解,提升废水处理效率。引入智能曝气调控及合成菌群构建等微生物治理新技术,对微生物降解行为进行评估,结果表明,高活性复合菌群与功能合成菌群在降解速率与酶促活性等方面具有优势。科学筛选菌群并优化反应条件,同时采用智能化装备,可显著提升微生物处理体系的降解效果,实现废水有机污染物的高效治理。
参考文献
[1]方诗韵,甘利红,何雨寒,等.北部湾水体持久性有机污染物和塑料降解功能基因多样性及其时空分布特征研究[J].水生态学杂志,2025,46(5):152-162.
[2]徐静怡,傅志宏,易锌琴,等.微生物介导的水体重金属-有机物复合污染修复机制及其应用[J].南昌大学学报(理科版),2025,49(2):222-232.
[3]李岳,肖紫鸣.微生物降解在有机污染物土壤修复中的应用及机理研究[J].中国轮胎资源综合利用,2024(10):32-34.
[4]罗雅嫣,汤蕙齐,李翼远,等.混合有机磷阻燃剂污染物的微生物降解特性及途径[J].中国环境科学,2024,44(6):3434-3441.
[5]张昕初.固定化微生物技术在难降解有机污染物治理中的研究进展[J].节能与环保,2022(9):28-29.










